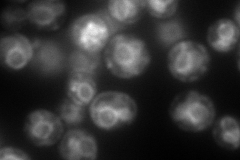
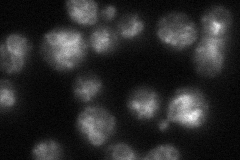

View description
Diacylglycerol pyrophosphate (DGPP) phosphatase, zinc-regulated vacuolar membrane-associated lipid phosphatase, dephosphorylates DGPP to phosphatidate (PA) and Pi, then PA to diacylglycerol; involved in lipid signaling and cell metabolism
Localization:
Intensity:
Fold change:
Significance:
-
C’ GFP library in SD

below threshold14.9 -
N' NOP1pr-GFP in SD

vacuole membrane155.498 -
N' TEF2pr-mCherry in SD
ER,vacuole230.471 -
N' NATIVEpr-GFP in SD
vacuole membrane49.3513 -
N' TEF2pr-VC and Cyto-VN in SD

punctate,vacuole membrane32.5631 -
C’ GFP library in SD+DTT

cytosol14.680.98No -
C’ GFP library in SD+H2O2

cytosol13.940.93No -
C’ GFP library in Starvation Media

cytosol16.481.1No -
C’ GFP library on the background of Pup2-DaMP

below threshold -
C’ GFP library on the background of CCT mutant

below threshold15.20241.01951No
